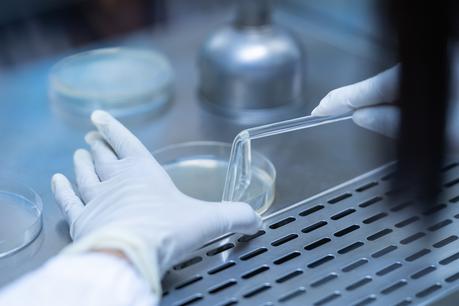
C’est une grande innovation à venir, celle d'implants à base de cellules souches qui sécrètent ici avec succès- de l'insuline chez les patients atteints de diabète de type 1 (Visuel Adobe Stock 279923619). C’est une grande innovation à venir, celle d'implants à base de cellules souches qui sécrètent ici avec succès- de l'insuline chez les patients atteints de diabète de type 1 (Visuel Adobe Stock 279923619).

C’est une grande innovation à venir, celle d'implants à base de cellules souches qui sécrètent ici avec succès- de l'insuline chez les patients atteints de diabète de type 1. Les résultats intermédiaires de cet essai clinique multicentrique démontrent la « faisabilité » de la sécrétion d'insuline à partir de cellules greffées chez des patients atteints de diabète de type 1. De plus ces premières données, publiées dans la revue Cell Stem Cell confirment également l'innocuité, la tolérabilité et l'efficacité de ce type d’implants biologiques.
Un siècle après la découverte de l'hormone insuline, le diabète de type 1 met toujours la vie en danger. La maladie se caractérise par la destruction des cellules β productrices d'insuline dans les îlots de Langerhans du pancréas, entraînant des niveaux élevés de glycémie. Ces implants constitués de cellules endodermiques pancréatiques dérivées de cellules souches pluripotentes humaines (CSP), pourraient, cette fois changer la donne. Testés chez 26 patients, ces implants cellulaires ne démontrent pas, à ce stade, des effets cliniques significatifs chez les participants diabétiques, mais révèlent en revanche leur capacité à induire une sécrétion d'insuline via les cellules souches qui les composent.


Un premier pas vers un approvisionnement illimité et endogène de cellules productrices d'insuline
Ce test n’est qu’une étape mais donne de l'espoir aux personnes vivant avec le diabète de type 1 de retrouver le moyen de sécréter à nouveau l’insuline, explique en substance l’auteur principal, le Dr Eelco de Koning du Leiden University Medical Center : « Malgré l'absence de constat d’effets cliniques pertinents, notre étude est une étape importante du développement de thérapies de remplacement cellulaire dérivées de cellules souches pluripotentes humaines ».
Car ces implants « cellulaires » survivent et la fonctionnalité des cellules perdure un an après la greffe. Ils constituent une alternative attendue et prometteuse aux insulinothérapies qui abaissent bien les niveaux de glucose mais sans les normaliser complètement et durablement. De plus, les systèmes modernes d'administration d'insuline peuvent être difficiles à porter pendant de longues périodes, peuvent parfois dysfonctionner ou entraîner des complications à long terme. Si la thérapie de remplacement des îlots de Langerhans semble une alternative intéressante, car elle restaure la sécrétion d'insuline dans le corps, les donneurs sont rares. Ces défis soulignent la nécessité d'un autre moyen d’approvisionner le corps en cellules productrices d'insuline et en grand nombre.
La piste des cellules souches pluripotentes humaines progresse. En 2006, les scientifiques de Novocell (maintenant ViaCyte) ont documenté un protocole en plusieurs étapes permettant la différenciation des cellules souches embryonnaires humaines en cellules endodermiques pancréatiques immatures. Ce protocole par étapes manipulant les voies de signalisation clés était basé sur le développement embryonnaire du pancréas. Des études de suivi ont montré que ces cellules endodermiques pancréatiques étaient capables de mûrir davantage et de devenir pleinement fonctionnelles lorsqu'elles étaient implantées dans des modèles animaux. Sur la base de ces résultats, des essais cliniques ont été lancés en utilisant ces cellules endodermiques pancréatiques.
Cet essai clinique de phase I/II prend dignement la suite : des cellules de l'endoderme pancréatique ont été placées dans des dispositifs de macroencapsulation non immunoprotecteurs (« ouverts »), qui ont permis une vascularisation directe des cellules, et implantées sous la peau chez des patients atteints de type 1 Diabète. L'utilisation de cellules tierces prêtes à l'emploi dans cette stratégie de remplacement des îlots de Langerhans à base de cellules souches nécessitait des agents immunosuppresseurs, qui protègent contre le rejet de greffe mais pouvaient provoquer des effets secondaires majeurs, tels que le cancer et les infections. Les participants ont subi un régime de traitement immunosuppresseur couramment utilisé dans les procédures de transplantation d'îlots de Langerhans.
- Les cellules de l'endoderme pancréatique PEC-01 ont bien survécu et se sont transformées en cellules sécrétant de l'insuline et sensibles au glucose dans les 26 semaines suivant l'implantation ;
- au cours du suivi d’1 an, les patients ont présenté des besoins en insuline réduits de 20 % et passaient 13 % plus de temps dans la plage de glycémie cible. Dans l'ensemble, les implants ont été bien tolérés sans événements indésirables graves liés à la greffe.
- Cet essai apporte ainsi les premières preuves que ces cellules PEC-01 dérivés de cellules souches peuvent devenir des cellules β matures, sensibles au glucose et productrices d'insuline in vivo chez les patients atteints de diabète de type 1.
- 2 patients ont présenté des événements indésirables graves associés au protocole d'immunosuppression.
Enfin, parmi les limites de l’essai, les chercheurs signalent l’absence de groupe témoin et le petit nombre de participants.
« La route clinique vers la mise en œuvre du traitement de remplacement des îlots de Langerhans dérivé de cellules souches pour le diabète de type 1 sera probablement longue et sinueuse. Jusque-là, la transplantation d'îlots de Langerhans reste une option thérapeutique pour un petit groupe de patients. Mais l'ère des thérapies innovantes de remplacement des îlots de Langerhans par cellules souches pour le traitement du diabète, a bien commencé ».
Source: Cell Stem Cell 2 Dec, 2021 DOI: 10.1016/j.stem.2021.10.003 Implanted pluripotent stem cell-derived pancreatic endoderm cells secrete glucose-responsive C-peptide in patients with type 1 diabetes
Lire aussi : DIABÈTE de TYPE 1 : La thérapie par cellules souches qui s’inspire du pancréas
Équipe de rédaction SantélogDéc 21, 2021Rédaction Santé log
